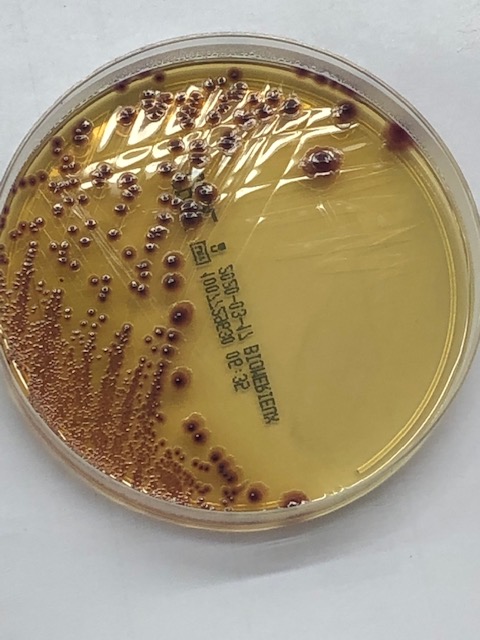

Es defineix com a bacteriúria asimptomàtica l’aïllament bacterià en un urinocultiu, recollit de forma correcte, sense que existeixi simptomatologia urinària acompanyant. En moltes ocasions la bacteriúria asimptomàtica s’associa a piúria que tampoc es definitòria d’infecció urinària. Des del punt de vista epidemiològic la bacteriúria asimptomàtica incrementa la seva prevalença de forma directament proporcional a l’edat,Sigue leyendo «Bacteriúria asimptomàtica»
Archivo de categoría: Multiresistències
Mapa de resistències de la zona (2018)
Mostres respiratòries Coprocultius Urinocultius S. aureus Indicadors
La resistència als antibiòtics
Els antibiòtics eliminen els bacteris responsables de les infeccions. Actualment hi ha antibiòtics per combatre gairebé tots els tipus de bacteris, però el seu ús generalitzat i de vegades incorrecte, ha fet que cada vegada hi hagi més bacteris resistents. Que és la resistència antibiòtica? La resistència als antibiòtics és la capacitat que tenen elsSigue leyendo «La resistència als antibiòtics»